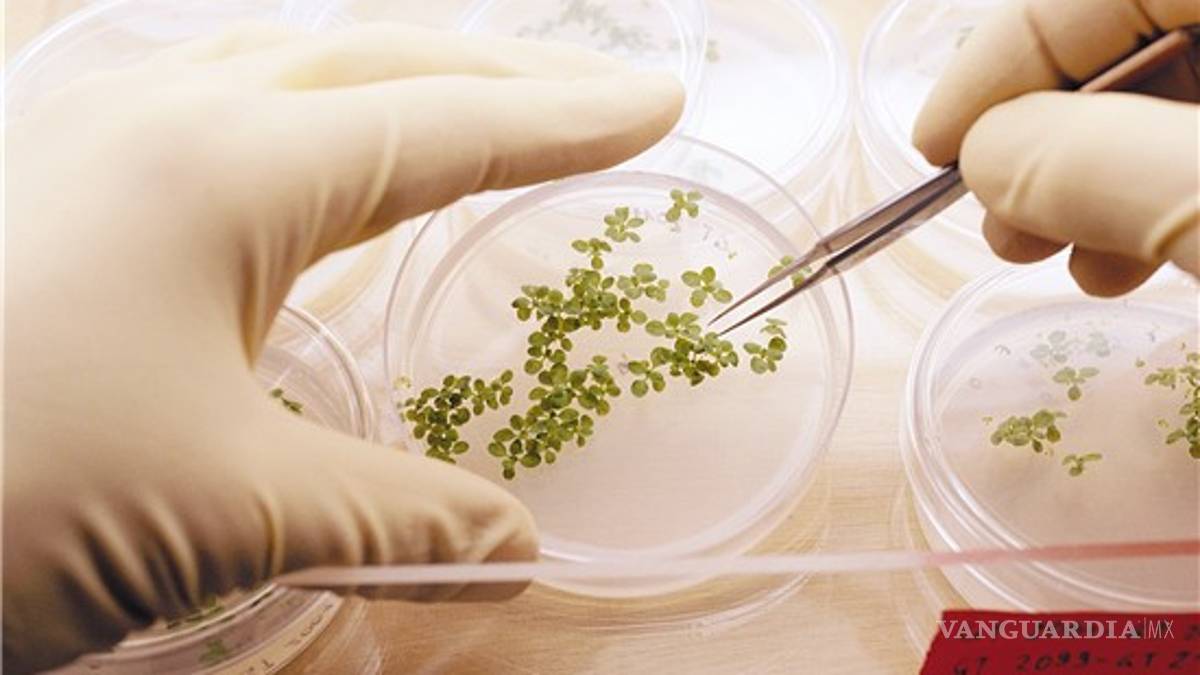

Puerto Rico deja de ser la única jurisdicción de EU sin una ley sobre ADN
COMPARTIR
La nueva legislación busca "proveer un mecanismo científico para probar la inocencia de personas que han sido erróneamente encarceladas"
Puerto Rico dejó de ser la única jurisdicción estadounidense sin una ley sobre ADN para condenados, tras la firma de la norma que provee un mecanismo científico para probar la inocencia de personas convictas erróneamente
El gobernador de Puerto Rico, Alejandro García Padilla, firmó el proyecto de la Cámara 2570, que da paso a la Ley de Análisis de ADN Post Sentencia, según informó a través de un comunicado difundido hoy el Ejecutivo de la isla caribeña.
La nueva legislación, según el comunicado, busca "proveer un mecanismo científico para probar la inocencia de personas que han sido erróneamente encarceladas".
"Con esta nueva ley se establecerá el procedimiento para que la persona convicta pueda solicitar un análisis genético de ADN sobre evidencia en posesión del Gobierno que nunca se analizó, evidencia nueva o evidencia que a pesar de ser analizada aún haya una legítima duda acerca de la certeza de los resultados", se matiza.
García Padilla, al convertir en ley en proyecto con la estampa de su firma, brinda herramientas al sistema de justicia "para que sea uno más justo e imparcial y en el que se juzguen a sus ciudadanos al amparo de la igual protección de las leyes, el debido proceso de ley y la presunción de inocencia", apunta el comunicado.
García Padilla firmó el documento que convierte el proyecto en la Ley de Análisis de ADN Post Sentencia acompañado por el decano de la Facultad de Derecho de la Universidad de Puerto Rico, Julio Fontanet Maldonado, quien mostró su satisfacción por las posibilidades que abre disponer en la isla caribeña de esta nueva normativa.
El presidente del Colegio de Abogados de Puerto Rico, Mark Anthony Bimbela, señaló a través de un comunicado que se siente satisfecho y esperanzado con la legislación aprobada que permitirá la realización de pruebas de ADN a personas convictas.
"Con mucha satisfacción hemos recibido la noticia de que el proyecto que permite pruebas de ADN a personas convictas, bajo ciertas condiciones, se convirtió en ley. Tenemos la esperanza de que con esta nueva ley se puedan esclarecer muchos casos", sostuvo.
La legislación aprobada establece un procedimiento para la realización de pruebas genéticas de ADN a aquellas personas convictas que puedan demostrar que existe nueva evidencia o evidencia bajo la posesión del Estado, no considerada en juicio y que dicha evidencia podría revocar la convicción.
Puerto Rico era la única jurisdicción todavía de Estados Unidos que no tenía una ley de ADN, impulsada por la organización Inoccence Project.
El Colegio de Abogados de Puerto Rico respaldó sin reserva alguna la medida, autoría de los legisladores Charlie Hernández, Luis Vega Ramos y la portavoz de la minoría, Jennifer González.
Bimbela indicó que la medida, que garantiza todavía más el debido proceso de ley y la búsqueda de la verdad, pone de manifiesto que se pueden alcanzar proyectos beneficiosos para Puerto Rico y los derechos democráticos sin divisiones políticas.
"Hemos visto cómo esta medida pudo aprobarse unánimemente por miembros de los dos partidos en la Cámara de Representantes y en el Senado", dijo, tras felicitar a la Asamblea Legislativa "por haber dejado a un lado la división partidista para colocar al frente los derechos civiles y democráticos de la ciudadanía".
El pasado 12 de septiembre, el Colegio aprobó en su Asamblea 175 una resolución apoyando la aprobación de la medida e instando a su firma por parte del gobernador Alejandro García Padilla.
Según Innocence Project, en Estados Unidos el 75 % de los excarcelados gracias a sus pruebas de ADN fueron reconocidos por testigos en ruedas de reconocimiento.
La organización destaca que a diferencia del recuerdo subjetivo o influenciado de los testigos o los interrogatorios, el ADN es una prueba científica.
Innocence Project defiende que la ciencia es el mejor medio para cambiar el actual sistema y evitar futuras injusticias.








